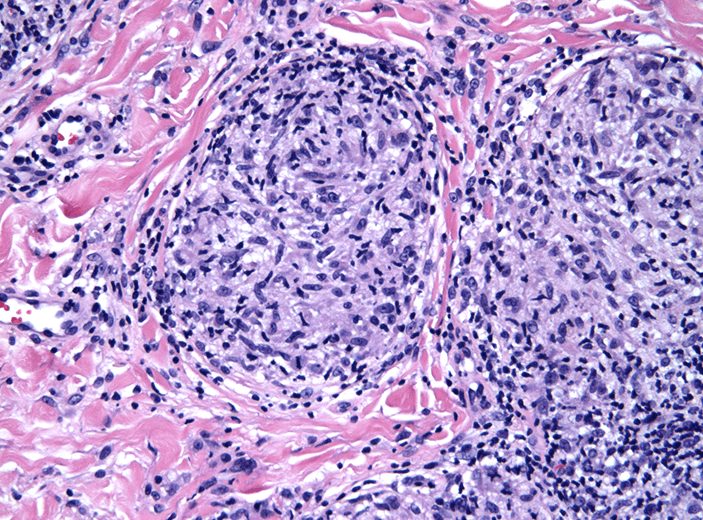

What is
Erythema Nodosum
Who am I? 
What is
treponema pallidum (syphilis)
True or false: Cutaneous manifestations of TB are common
What is
False (<2%)
 What disease do you commonly see this rash in?
What disease do you commonly see this rash in?
What is
Systemic Lupus Erythermatosus
What is the name of an autoimmune severe blistering disease found on mucous membranes that rupture with minimal pressure?
What is
Pemphigus Vulgaris
(vs Bullous Pemphigoid which rarely involves mucous membranes)
What is erythema nodosum?
What is
a delayed hypersensitivity reaction that looks like erythematous tender nodules on the shins
A rash on what part of the body is an important clue for secondary syphilis?
What is
the palms and soles (can be anywhere)
You suspect a patient has skin manifestations of Tuberculosis, what tests do you order to confirm?
What is
Skin biopsy
Acid-fast bacilli smear
Mycobacterial culture (gold standard)
Tuberculin skin test or IGRA
What causes Lepromatous leprosy?
What is
- Acid fast bacilli (M. leprae and M. lepromatosis)
 What disease is associated with Gottron's papules?
What disease is associated with Gottron's papules?
What is
Dermatomyositis
What am I?

What is
Cutaneous Sarcoidosis
When during the course of infection would you expect to find skin lesions in syphilis?
What is
4 to 6 weeks
What disease is associated with nodules that have an "apple-jelly" color?

What is
Lupus Vulgaris (TB hematogenous spread to the skin)
How is discoid lupus different from lupus?
 What is
What is
Cutaneous lupus (discoid) does not always progress to systemic disease
What is acrophacy and common cause?
What is
Clubbing (cyanosis due to cardiac/pulmonary disease)

What pathology description/finding would be present in a biopsy of cutaneous sarcoidosis?
What is
Noncaseating granulomas
How would you describe me? This patient has secondary syphilis

What is
multiple discrete, hyperpigmented scaly plaques on the abdomen
What are three ways TB can infect the skin?
What is
Contiguous spread
Hematogenous spread
Inoculation from exogenous source
A patient comes to clinic complaining of discoloration and pain in their fingers when cold, what is this called?
What is
Raynaud's phenomenon (occurs in up to 50% of SLE)
What systemic disease causes fibrotic changes in the skin, blood vessels, lungs, heart, kidneys and GI tract?
What is
Scleroderma ("hard skin")
How common are skin findings in sarcoidosis and how do they commonly present?
What is
25%
Discrete, red, raised dermal nodules w/ central scarring 
What forms may the rash of secondary syphilis take?
What is
smooth, scaly, pustular, diffuse, nodular, symmetric macular or papular rash of the entire trunk and extremities
What factors change the threshold for a positive TB skin test?
What is
HIV infection
Close contact with person with TB
Immunosuppressed
Abnormal CXR
People in high risk settings (prison, healthcare)
Comorbidities (DM, dialysis)
<4 years old
What specific antibodies do you test for if you suspect SLE and patient has a positive ANA test?
What is
anti-dsDNA
anti-Smith
(also consider anti-Ro/La, Anti U1 RNP, CRP, ESR)
What is the skin finding in the triad of familial adenomatous polyposis (skin*, osteomas, adenomatous GI polyposis)?
What is
Epidermal cysts (found in >50%, on face neck and scalp )
)